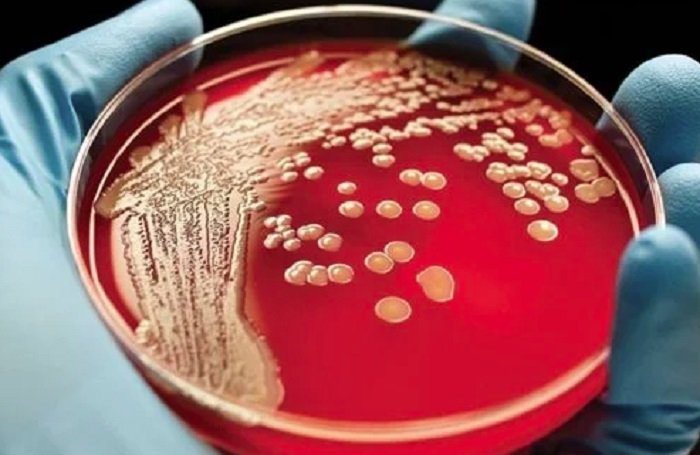
ليست للوقاية بل للعلاج.. خبير روسي يكشف أسرار اللقاح الذكي للقضاء على الخلايا السرطانية ليست للوقاية بل للعلاج.. خبير روسي يكشف أسرار اللقاح الذكي للقضاء على الخلايا السرطانية

ليست للوقاية بل للعلاج.. خبير روسي يكشف أسرار اللقاح الذكي للقضاء على الخلايا السرطانية
كتبت: منى حمدان
فجر الدكتور يفغيني بورتسيف، رئيس قسم زراعة النخاع بمستشفى “موروزوف” في موسكو، مفاجآت هامة حول مستقبل علاج السرطان باللقاحات.
وفي لقاء خاص عبر برنامج “قصارى القول” على قناة RT عربية، أوضح بورتسيف الفرق الجوهري بين العلاجات التقليدية والتقنيات الحديثة التي تتبناها روسيا حالياً.
لقاحات السرطان: علاج ذكي يستهدف الخلايا المريضة
أكد الدكتور بورتسيف أن اللقاحات التي يتم الحديث عنها هي لقاحات علاجية (Therapeutic Vaccines) وليست استباقية للوقاية من المرض. وتتميز هذه اللقاحات عن العلاج الكيميائي بالتالي:
الدقة العالية: تستهدف “المستضدات” الموجودة على سطح خلايا الورم فقط.
حماية الخلايا السليمة: على عكس الكيماوي، لا تؤثر هذه اللقاحات على الخلايا السليمة، مما يقلل الآثار الجانبية ويزيد الفعالية.
نجاحات مبهرة في علاج سرطان الدم
كشف الطبيب الروسي أن نسبة النجاح في علاج سرطان الدم وصلت إلى 85% بفضل هذه التقنيات.
ومع ذلك، أشار إلى أن بعض الأورام مثل “سرطان البنكرياس” لا تزال تشكل تحدياً بسبب اكتشافها المتأخر، مما يتطلب استمرار اللجوء للعلاج الكيميائي.
تكلفة علاج السرطان في روسيا وفرص الأجانب
تعد تكلفة إنتاج هذه اللقاحات مرتفعة جداً، حيث تصل إلى 27 مليون روبل للشخص الواحد (ما يعادل أكثر من 300 ألف دولار تقريباً).
للمواطنين الروس: يتم تقديم العلاج مجاناً بالكامل.
للأجانب: أكد بورتسيف أن العلاج متاح للأجانب عبر التواصل مع المراكز المتخصصة.
أشهر مراكز علاج الأورام في روسيا
إذا كنت تبحث عن أفضل مستشفيات علاج السرطان في روسيا، فقد حدد الدكتور بورتسيف المراكز التالية:
- مستشفى موروزوف للأطفال (موسكو).
- مركز بلوخين للأورام.
- مركز ديما روغاتشوف.
- مستشفى رايسا غورباتشوفا (سانت بطرسبورغ).
أسباب زيادة الإصابات وحقيقة علاقة “لقاح كوفيد” بالسرطان
أرجع بورتسيف ارتفاع إحصائيات الإصابة بالسرطان (خاصة وصول حالات سرطان الدم بين الأطفال في روسيا إلى 155 ألف حالة سنوياً) إلى تطور أدوات التشخيص التي سمحت باكتشاف حالات كانت مجهولة سابقاً.
هل تسبب لقاحات كوفيد-19 السرطان؟ نفى الدكتور بورتسيف وجود أي دليل علمي يربط بين لقاحات كورونا وازدياد الأورام، مؤكداً أن إثبات مثل هذه الادعاءات يحتاج إلى دراسات تستمر لعشرات السنين.
كيف نتجنب الإصابة بالسرطان؟
ختم الخبير الروسي نصائحه بالتأكيد على أن النظام الغذائي والحياة الصحية هما حجر الأساس للوقاية، مع الإشارة إلى أن السرطانات الجينية والسرطانات التي تصيب الأطفال لا يوجد لها طرق وقاية واضحة لأنها غالباً ما ترتبط بلحظة الولادة أو عوامل وراثية.
- للمزيد : تابع العاصمة والناس، وللتواصل الاجتماعي تابعنا علي فيسبوك وتويتر .








